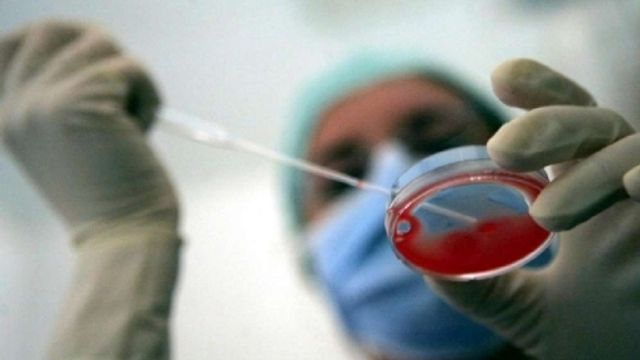

La fecondazione eterologa costerà tra i 400 e i 600 euro. "E' stata definita una tariffa unica" ha detto il presidente della Conferenza delle Regioni, Sergio Chiamparino, che considera la pratica all'interno dei Lea, i Livelli essenziali di assistenza. Il costo effettivo dipenderà dal ticket fissato nelle singole Regioni. "Fa eccezione la Lombardia, che ha ritenuto di far pagare interamente il costo della fecondazione eterologa" ha precisato Chiamparino.
"Vogliamo che il Governo dica subito se inserisce questa prestazione nei Lea". Con questa dichiarazione l'assessore all'Economia della Regione Lombardia, Massimo Garavaglia, ha espresso tutta la sua impazienza sulla questione della fecondazione eterologa. "Se è così - ha aggiunto - se ne assume l'onere e il problema viene risolto alla radice. Non è corretto, infatti, che una coppia lombarda, anche se va in Emilia Romagna, solo per fare un esempio, debba pagare interamente la fecondazione eterologa". Alle sue parole fanno eco quelle di Sergio Chiamparino: "Ci auguriamo che il Governo inserisca l'eterologa nei Livelli essenziali di assistenza che saranno pronti entro la fine dell'anno".
Il no della Lombardia - Per i lombardi al momento l'eterologa costerà tra i 1500 e i 4000 euro, a seconda della tecnica di fecondazione scelta e includendo anche le varie prestazioni necessarie a effettuare la pratica (esami del sangue, ecografie, ecc.). La Regione Lombardia ha comunicato che fino a quando le prestazioni di procreazione medicalmente assistita non verranno ricomprese nel DPCM che individua i Lea (Livelli essenziali di assistenza), le stesse saranno a carico dell'assistito anche qualora venissero rese da strutture di altre Regioni.
Il documento della Conferenza delle Regioni - Dopo l'approvazione in Conferenza delle Regioni nella seduta del 4 settembre del documento sulle problematiche relative alla fecondazione eterologa, le Regioni ribadiscono il principio di includere la procreazione medicalmente assistita (PMA) tra i Lea. In attesa, come richiesto, che sia l'omologa che l'eterologa vengano inserite nel DPCM sui livelli essenziali di assistenza, che dovrà essere rivisto entro la fine dell'anno come previsto dal Patto per la Salute 2014-2016. L'obiettivo è quello dichiarato di garantire sia il diritto alla fecondazione eterologa stabilito dalla sentenza della Corte Costituzionale n.162/2014 che la sicurezza e tutela della salute dei soggetti interessati.
La decisione delle Regioni di fissare una tariffa unica convenzionale è stata definita una tappa obbligata per regolare le eventuali compensazioni relative alla mobilità interregionale, "continuando a dimostrare un forte senso di unita' e capacità di governance del sistema sanitario". Le Regioni e le Province Autonome hanno pertanto condiviso questa proposta di tariffe convenzionali per la relativa compensazione della mobilità interregionale, differenziandole per le tre attività di assistenza e ambulatorio che la fecondazione eterologa ricomprende: 1.500 euro per fecondazione eterologa con seme da donatore con inseminazione intrauterina; 3500 euro fecondazione eterologa con seme da donatore in vitro; 4000 euro per fecondazione eterologa con ovociti da donatrice.
La compartecipazione alla spesa riguarderà la somma dei ticket per le prestazioni effettuate per questa tecnica di fecondazione. Per quanto riguarda, invece, la compensazione per le prestazioni effettuate su pazienti provenienti da altre Regioni o Province Autonome, ogni Regione riceverà dalle altre la differenza tra la tariffa convenzionalmente definita e quanto già introitato attraverso i ticket, "ad eccezione di quanto già precisato per la Regione Lombardia".